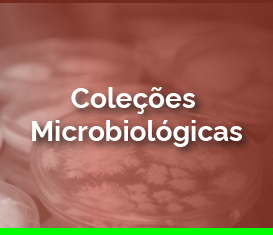
coleções-03.png

O Programa Coleções
O Programa de Coleções Científicas Biológicas – PCCB é o Programa Institucional do INPA que integra e coordena as iniciativas e atividades para manter e consolidar os acervos de nove coleções biológicas organizadas em três grandes áreas temáticas: Botânicas, Microbiológicas e Zoológicas. Através de inúmeros desafios e conquistas ao longo de mais de seis décadas, as Coleções Biológicas do INPA têm consolidado seus papéis como acervos de referência da biodiversidade amazônica.
As nove Coleções abrigam hoje em seus acervos os maiores repositórios da biodiversidade amazônica ex-situ na região e até mesmo no país (> 1,2 milhão de exemplares e/ou lotes de exemplares), o que significa manter em condições adequadas e disponibilizar para consulta, informações e material testemunho sobre a biodiversidade de uma região maior que vários países do globo (aproximadamente 7 milhões de km2), sendo considerada a mais rica em espécies de plantas, insetos e peixes de água doce do planeta. O PCCB abrange amostras de todas as drenagens amazônicas, inclusive das drenagens que se originam fora da Amazônia brasileira, de imenso valor científico para estudos de evolução de fauna e flora, distribuição geográfica, reconhecimento de áreas de alta diversidade de espécies e outras.
Os acervos mais antigos do INPA possuem mais de 60 anos e são base para a identificação de inúmeros padrões ecológicos e evolutivos e descrição de centenas de espécies da biodiversidade amazônica. Ao mesmo tempo, também testemunharam mudanças de grande porte na biota amazônica, desde a construção de hidrelétricas, a desmatamentos diversos relacionados às aberturas de estradas, construção de gasodutos e linhas transmissão, estabelecimento de pastagens e implantação de monocultura, e impactos das mudanças climáticas globais.
Assim, as informações contidas nos acervos da biota amazônica mantidos no INPA são de valor inestimável, visto que avaliações de perda de áreas, perda de diversidade, erosão de estoques genéticos e impactos de contaminação e mudanças climáticas sobre a biota passam pelo conhecimento acumulado e conservado nos acervos no INPA. Esses acervos trazem o registro da biodiversidade de áreas que nunca mais terão a sua diversidade natural recuperada , sendo os únicos testemunhos da existência de várias espécies inclusive já extintas localmente, ou de populações e comunidades biológicas sob fortes impactos de alterações ambientais.
As coleções têm por finalidade básica manter representantes da biodiversidade amazônica em condições ex-situ, seja vivo ou fixado, elaborando e mantendo bancos de dados para fins de pesquisa. O público-alvo das coleções é formado por pesquisadores e estudantes de pós-graduação, ou seja, a sociedade acadêmica nacional e internacional. A manutenção desses banco de dados também tem finalidade de fomentar pesquisas científicas e orientar tomadores de decisão de políticas públicas tanto a nível nacional, estadual, municipal ou regional.
O PCCB é coordenado pela Dra. Fernanda de Pinho Werneck e o substituto, Dr. Michael John Gilbert Hopkins, e está constituído pelas coleções científicas e 09 curadorias que as compõem.
ADMINISTRAÇÃO / PCCB
Coordenadora: Dra. Fernanda de Pinho Werneck
Coordenador Substituto: Dr. Michael John Gilbert Hopkins
Assistente de secretaria: Ronnezza Campos Pedrett